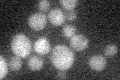
YNL251C
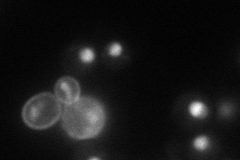
YNL251C
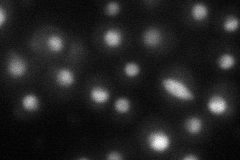
YNL251C

View description
RNA-binding protein that interacts with the C-terminal domain of the RNA polymerase II large subunit (Rpo21p), preferentially at phosphorylated Ser5; required for transcription termination and 3' end maturation of nonpolyadenylated RNAs
Localization:
Intensity:
Fold change:
Significance:
-
C’ GFP library in SD
below threshold17.8 -
N' NOP1pr-GFP in SD
nucleus66.2354 -
N' TEF2pr-mCherry in SD
nucleus31.1393 -
N' NATIVEpr-GFP in SD

nucleus79.9311 -
N' TEF2pr-VC and Cyto-VN in SD

nucleus35.5263 -
C’ GFP library in SD+DTT

cytosol16.390.92No -
C’ GFP library in SD+H2O2

cytosol17.430.97No -
C’ GFP library in Starvation Media

cytosol15.280.85No -
C’ GFP library on the background of Pup2-DaMP

N/A -
C’ GFP library on the background of CCT mutant

N/A0N/AYes
